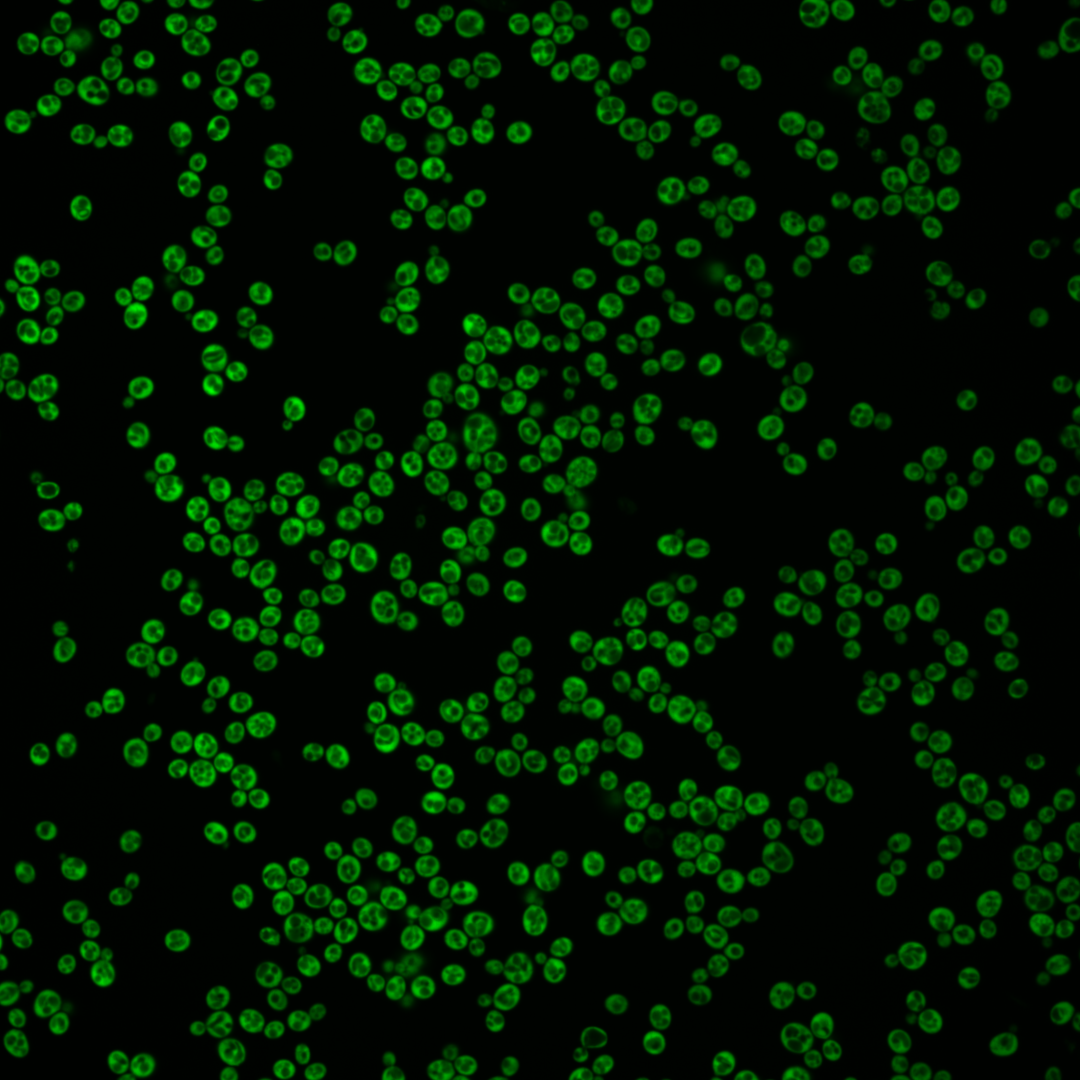
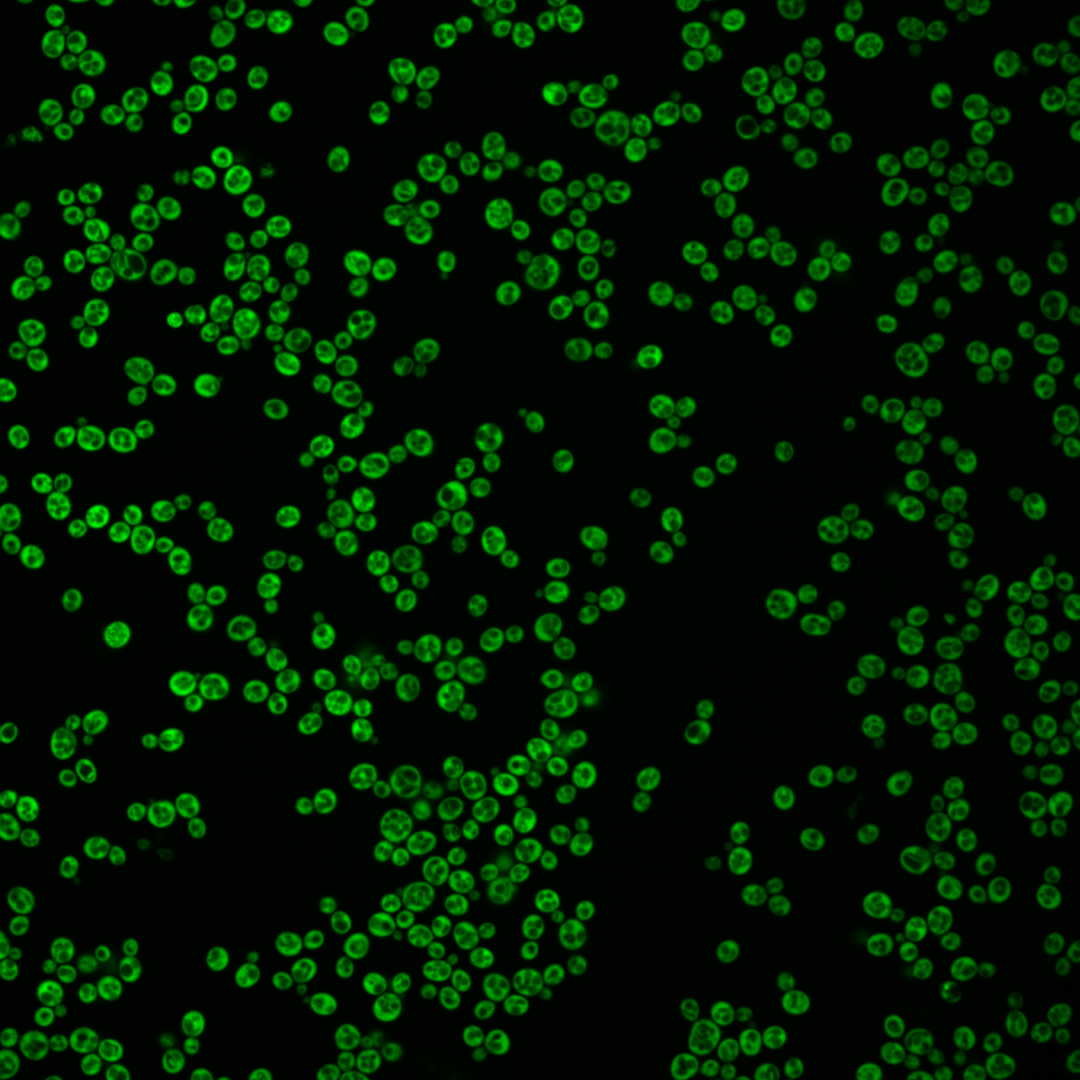
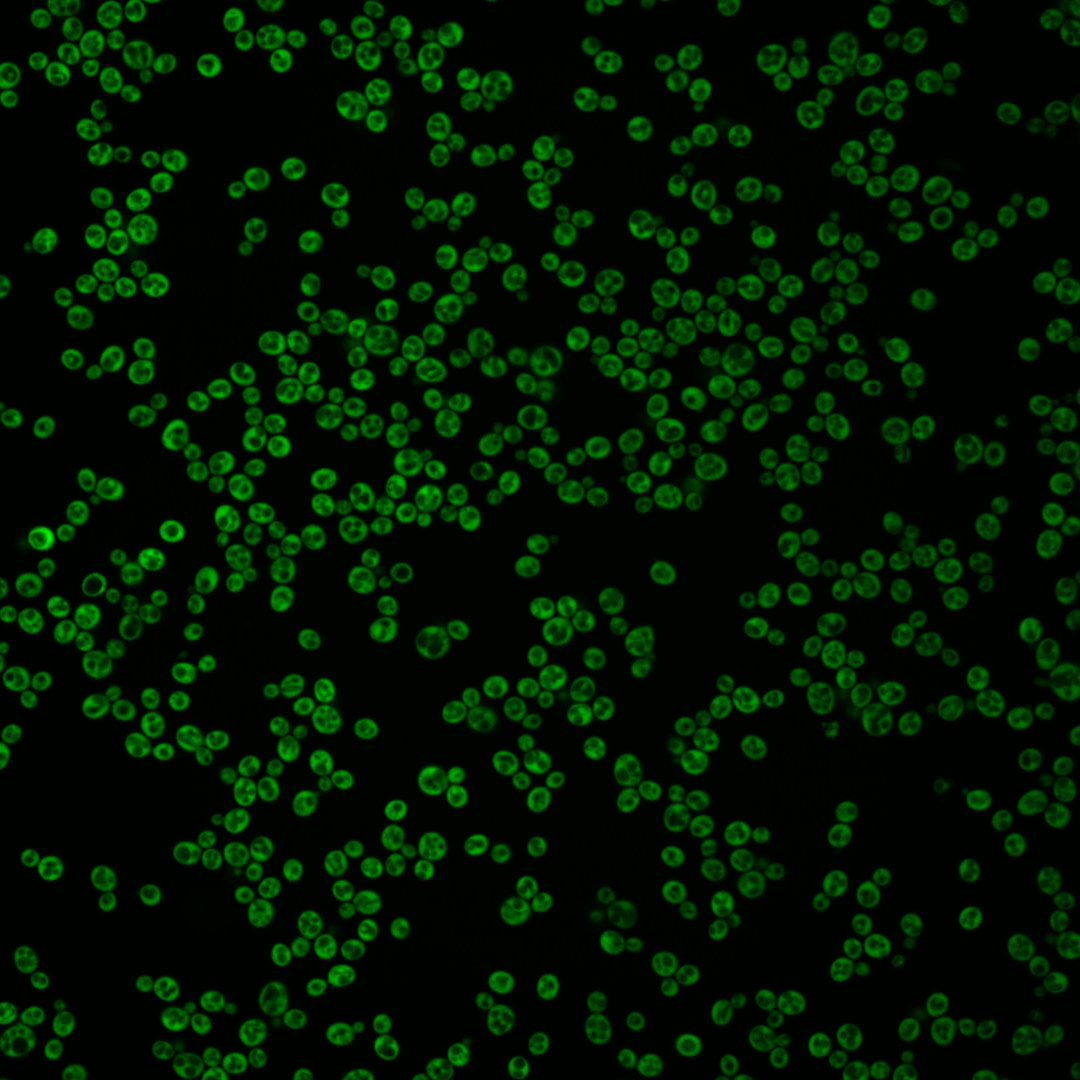
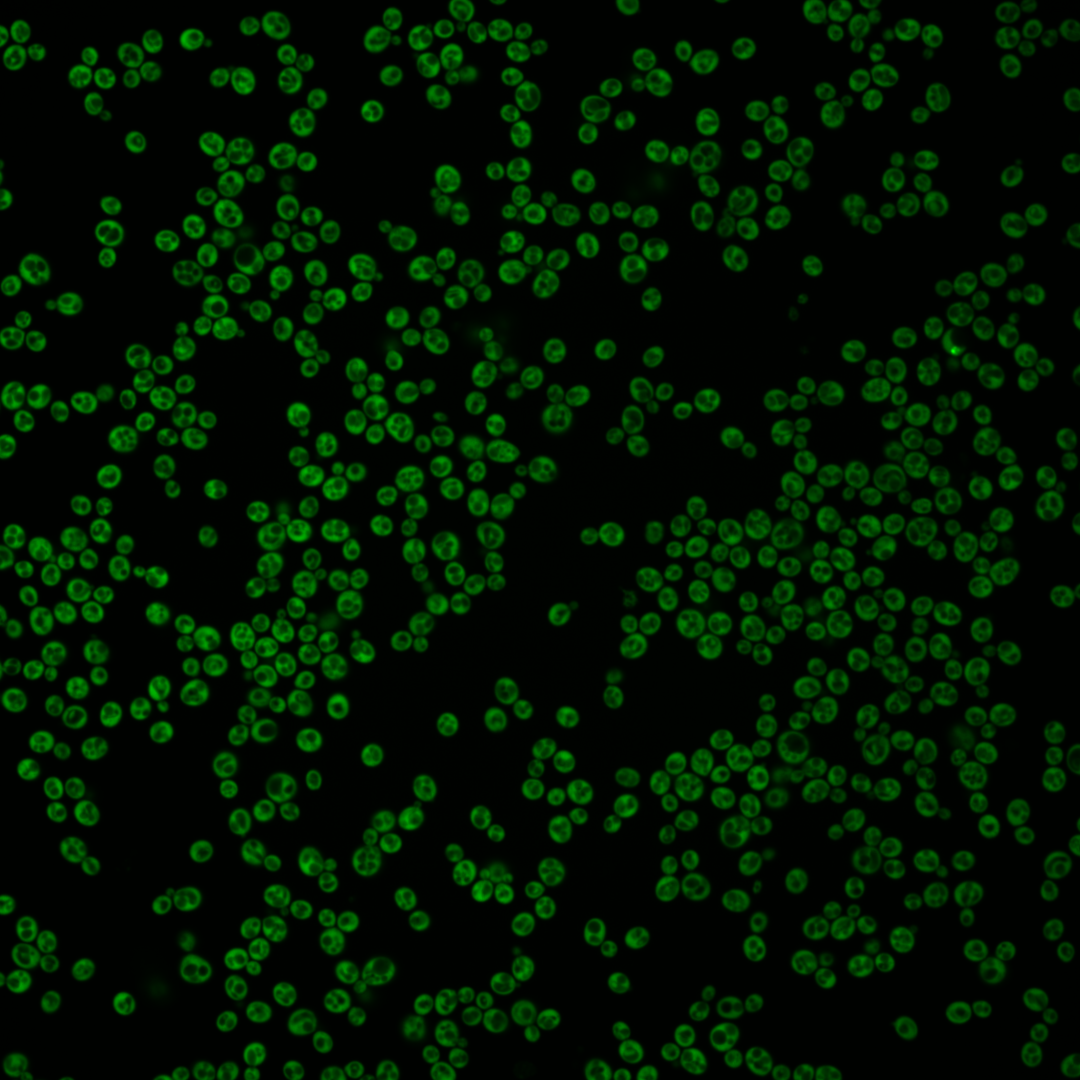

| Standard name | |
|---|---|
| Human Ortholog | |
| Description | Ribosomal 60S subunit protein L41B; comprises only 25 amino acids; rpl41a rpl41b double null mutant is viable; homologous to mammalian ribosomal protein L41, no bacterial homolog; RPL41B has a paralog, RPL41A, that arose from the whole genome duplication |
Micrographs




















































































Sub-cellular Localization
Yeast GFP Assignment
Protein Abundance
Localization Change
External localization resources
| ensLOC | DeepLoc | |||||||||||||||||||||||
|---|---|---|---|---|---|---|---|---|---|---|---|---|---|---|---|---|---|---|---|---|---|---|---|---|
| Localization | WT1 | WT2 | WT3 | RAP60 | RAP140 | RAP220 | RAP300 | RAP380 | RAP460 | RAP540 | RAP620 | RAP700 | HU80 | HU120 | HU160 | rpd3Δ_1 | rpd3Δ_2 | rpd3Δ_3 | WT1 | WT2 | WT3 | AF100 | AF140 | AF180 |
| Cortical Patches | 0 | – | 0 | 0 | 0 | 0 | 4 | 6 | 10 | 15 | 12 | 30 | 0 | 0 | 0 | 0 | 0 | 0 | 0 | 0 | 0 | 0 | 0 | 0 |
| Bud | 0 | – | 2 | 0 | 0 | 0 | 1 | 4 | 0 | 2 | 1 | 0 | 0 | 1 | 0 | 0 | 0 | 0 | 4 | 0 | 2 | 0 | 0 | 1 |
| Bud Neck | 0 | – | 0 | 0 | 0 | 0 | 0 | 0 | 0 | 0 | 0 | 0 | 0 | 0 | 0 | 0 | 0 | 0 | 0 | 0 | 0 | 0 | 0 | 0 |
| Bud Site | 0 | – | 0 | 0 | 0 | 0 | 0 | 0 | 0 | 0 | 0 | 0 | 0 | 0 | 0 | 0 | 0 | 0 | – | – | – | – | – | – |
| Cell Periphery | 1 | – | 0 | 1 | 2 | 9 | 16 | 19 | 15 | 36 | 17 | 31 | 0 | 1 | 3 | 2 | 1 | 2 | 0 | 0 | 0 | 0 | 0 | 0 |
| Cytoplasm | 438 | – | 222 | 374 | 401 | 386 | 429 | 417 | 302 | 348 | 342 | 336 | 86 | 176 | 153 | 176 | 138 | 160 | 426 | 41 | 201 | 19 | 146 | 118 |
| Endoplasmic Reticulum | 2 | – | 0 | 1 | 19 | 21 | 96 | 127 | 73 | 73 | 87 | 109 | 1 | 0 | 0 | 10 | 8 | 15 | 2 | 0 | 4 | 0 | 2 | 2 |
| Endosome | 0 | – | 0 | 0 | 0 | 0 | 0 | 0 | 0 | 0 | 0 | 0 | 0 | 0 | 0 | 0 | 0 | 0 | 0 | 0 | 0 | 0 | 0 | 0 |
| Golgi | 0 | – | 0 | 0 | 0 | 0 | 9 | 3 | 12 | 11 | 8 | 16 | 0 | 0 | 1 | 0 | 1 | 0 | 0 | 0 | 1 | 0 | 0 | 0 |
| Mitochondria | 0 | – | 1 | 0 | 0 | 0 | 1 | 1 | 7 | 11 | 15 | 28 | 1 | 0 | 0 | 1 | 3 | 1 | 0 | 1 | 1 | 0 | 0 | 0 |
| Nucleus | 0 | – | 0 | 0 | 0 | 0 | 1 | 0 | 1 | 0 | 0 | 0 | 0 | 0 | 0 | 0 | 0 | 0 | 1 | 0 | 0 | 0 | 0 | 0 |
| Nuclear Periphery | 0 | – | 0 | 0 | 0 | 0 | 0 | 0 | 0 | 0 | 0 | 0 | 0 | 0 | 0 | 0 | 0 | 0 | 0 | 0 | 1 | 0 | 0 | 0 |
| Nucleolus | 0 | – | 0 | 0 | 0 | 0 | 0 | 3 | 1 | 1 | 2 | 1 | 1 | 0 | 0 | 0 | 0 | 0 | 0 | 0 | 0 | 0 | 0 | 0 |
| Peroxisomes | 1 | – | 0 | 0 | 0 | 0 | 0 | 0 | 0 | 0 | 0 | 0 | 0 | 0 | 0 | 0 | 0 | 0 | 0 | 0 | 0 | 0 | 0 | 0 |
| SpindlePole | 0 | – | 0 | 0 | 0 | 0 | 0 | 0 | 0 | 0 | 0 | 0 | 0 | 0 | 0 | 0 | 0 | 0 | 0 | 0 | 0 | 0 | 0 | 0 |
| Vac/Vac Membrane | 0 | – | 0 | 0 | 0 | 0 | 1 | 4 | 0 | 3 | 1 | 2 | 1 | 0 | 1 | 0 | 1 | 0 | 3 | 0 | 2 | 0 | 1 | 1 |
| Unique Cell Count | 442 | 223 | 375 | 419 | 410 | 541 | 565 | 393 | 461 | 463 | 495 | 88 | 176 | 155 | 177 | 142 | 163 | 447 | 47 | 219 | 22 | 153 | 126 | |
| Labelled Cell Count | 442 | 225 | 376 | 422 | 416 | 558 | 584 | 421 | 500 | 485 | 553 | 90 | 178 | 158 | 189 | 152 | 178 | 447 | 47 | 219 | 22 | 153 | 126 | |
Yeast GFP Assignment
Protein Abundance
| Screen | WT1 | WT2 | WT3 | RAP60 | RAP140 | RAP220 | RAP300 | RAP380 | RAP460 | RAP540 | RAP620 | RAP700 | HU80 | HU120 | HU160 | rpd3Δ_1 | rpd3Δ_2 | rpd3Δ_3 | AF100 | AF140 | AF180 |
|---|---|---|---|---|---|---|---|---|---|---|---|---|---|---|---|---|---|---|---|---|---|
| Mean Cell GFP Intensity (1e-4) | 179.0 | – | 103.2 | 145.0 | 118.0 | 83.4 | 68.1 | 62.0 | 57.9 | 51.5 | 48.9 | 45.5 | 173.1 | 177.2 | 165.3 | 259.0 | 237.9 | 241.8 | – | 211.2 | 211.5 |
| Std Deviation (1e-4) | 39.5 | – | 31.9 | 26.3 | 22.9 | 15.8 | 16.1 | 14.9 | 13.7 | 13.0 | 10.8 | 10.8 | 37.2 | 39.4 | 36.0 | 56.0 | 77.2 | 67.3 | – | 40.6 | 48.4 |
| Intensity Change (Log2) | – | – | – | 0.49 | 0.19 | -0.31 | -0.6 | -0.74 | -0.83 | -1.0 | -1.08 | -1.18 | 0.75 | 0.78 | 0.68 | 1.33 | 1.2 | 1.23 | – | 1.03 | 1.04 |
Localization Change
| Localization | RAP60 | RAP140 | RAP220 | RAP300 | RAP380 | RAP460 | RAP540 | RAP620 | RAP700 | HU80 | HU120 | HU160 | rpd3Δ_1 | rpd3Δ_2 | rpd3Δ_3 |
|---|---|---|---|---|---|---|---|---|---|---|---|---|---|---|---|
| Cortical Patches | 0 | 0 | 0 | 0 | 0 | 0 | 0 | 0 | 3.8 | 0 | 0 | 0 | 0 | 0 | 0 |
| Bud | 0 | 0 | 0 | 0 | 0 | 0 | 0 | 0 | 0 | 0 | 0 | 0 | 0 | 0 | 0 |
| Bud Neck | 0 | 0 | 0 | 0 | 0 | 0 | 0 | 0 | 0 | 0 | 0 | 0 | 0 | 0 | 0 |
| Bud Site | 0 | 0 | 0 | 0 | 0 | 0 | 0 | 0 | 0 | 0 | 0 | 0 | 0 | 0 | 0 |
| Cell Periphery | 0 | 0 | 0 | 0 | 2.8 | 3.0 | 4.3 | 2.9 | 3.8 | 0 | 0 | 0 | 0 | 0 | 0 |
| Cytoplasm | 0.4 | -2.7 | -3.3 | -7.2 | -8.3 | -7.6 | -7.9 | -8.2 | -9.4 | -1.5 | 0.9 | -0.9 | -0.2 | -1.9 | -1.3 |
| Endoplasmic Reticulum | 0 | 3.2 | 3.4 | 6.7 | 7.7 | 6.9 | 6.3 | 6.9 | 7.6 | 0 | 0 | 0 | 0 | 0 | 4.6 |
| Endosome | 0 | 0 | 0 | 0 | 0 | 0 | 0 | 0 | 0 | 0 | 0 | 0 | 0 | 0 | 0 |
| Golgi | 0 | 0 | 0 | 0 | 0 | 0 | 0 | 0 | 0 | 0 | 0 | 0 | 0 | 0 | 0 |
| Mitochondria | 0 | 0 | 0 | 0 | 0 | 0 | 0 | 2.3 | 3.3 | 0 | 0 | 0 | 0 | 0 | 0 |
| Nucleus | 0 | 0 | 0 | 0 | 0 | 0 | 0 | 0 | 0 | 0 | 0 | 0 | 0 | 0 | 0 |
| Nuclear Periphery | 0 | 0 | 0 | 0 | 0 | 0 | 0 | 0 | 0 | 0 | 0 | 0 | 0 | 0 | 0 |
| Nucleolus | 0 | 0 | 0 | 0 | 0 | 0 | 0 | 0 | 0 | 0 | 0 | 0 | 0 | 0 | 0 |
| Peroxisomes | 0 | 0 | 0 | 0 | 0 | 0 | 0 | 0 | 0 | 0 | 0 | 0 | 0 | 0 | 0 |
| SpindlePole | 0 | 0 | 0 | 0 | 0 | 0 | 0 | 0 | 0 | 0 | 0 | 0 | 0 | 0 | 0 |
| Vacuole | 0 | 0 | 0 | 0 | 0 | 0 | 0 | 0 | 0 | 0 | 0 | 0 | 0 | 0 | 0 |
External localization resources
Images






























Protein Concentration and Protein Localization Data
| R1 | R2 | R3 | ||||||||||||||||
|---|---|---|---|---|---|---|---|---|---|---|---|---|---|---|---|---|---|---|
| G1 Pre-START | G1 Post-START | S/G2 | Metaphase | Anaphase | Telophase | G1 Pre-START | G1 Post-START | S/G2 | Metaphase | Anaphase | Telophase | G1 Pre-START | G1 Post-START | S/G2 | Metaphase | Anaphase | Telophase | |
| Concentration | 184.2252 | 253.9436 | 223.0844 | 219.3716 | 204.7563 | 106.1831 | 191.4682 | 225.4407 | 203.9917 | 191.9626 | 199.3631 | 213.8326 | 212.4937 | 281.701 | 246.9897 | 239.7586 | 160.4199 | 221.3297 |
| Actin | 0.0042 | 0.0002 | 0.0006 | 0.0017 | 0.0041 | 0.0002 | 0.0035 | 0.001 | 0.0017 | 0.0095 | 0.0004 | 0.0003 | 0.0017 | 0.0003 | 0.0172 | 0.0004 | 0.0059 | 0.001 |
| Bud | 0.0018 | 0.0008 | 0.0013 | 0.0018 | 0.005 | 0.0016 | 0.0023 | 0.0024 | 0.0027 | 0.0096 | 0.0029 | 0.0008 | 0.003 | 0.0014 | 0.002 | 0.0013 | 0.0032 | 0.0017 |
| Bud Neck | 0.0008 | 0.0009 | 0.001 | 0.0008 | 0.0016 | 0.0008 | 0.0009 | 0.0006 | 0.001 | 0.0008 | 0.0011 | 0.0008 | 0.0009 | 0.0005 | 0.0011 | 0.0009 | 0.0012 | 0.0005 |
| Bud Periphery | 0.0031 | 0.0008 | 0.0012 | 0.0017 | 0.0052 | 0.0023 | 0.0025 | 0.0012 | 0.0012 | 0.0225 | 0.0012 | 0.0002 | 0.0029 | 0.0005 | 0.0012 | 0.0008 | 0.0027 | 0.0008 |
| Bud Site | 0.0008 | 0.0009 | 0.0006 | 0.0007 | 0.0254 | 0.0004 | 0.001 | 0.0013 | 0.0011 | 0.002 | 0.0008 | 0 | 0.001 | 0.0007 | 0.0015 | 0.0005 | 0.0018 | 0.0002 |
| Cell Periphery | 0.0572 | 0.0625 | 0.0395 | 0.0299 | 0.0075 | 0.012 | 0.036 | 0.0199 | 0.0181 | 0.0182 | 0.0059 | 0.0002 | 0.03 | 0.014 | 0.0109 | 0.0442 | 0.0046 | 0.0025 |
| Cytoplasm | 0.5541 | 0.7464 | 0.6942 | 0.549 | 0.6007 | 0.2775 | 0.645 | 0.8701 | 0.7643 | 0.6399 | 0.6645 | 0.954 | 0.6509 | 0.8972 | 0.7745 | 0.6334 | 0.5664 | 0.722 |
| Cytoplasmic Foci | 0.0178 | 0.0007 | 0.0061 | 0.0012 | 0.0033 | 0.0033 | 0.0027 | 0.0018 | 0.0032 | 0.0009 | 0.0027 | 0.0017 | 0.0108 | 0.0008 | 0.0083 | 0.0013 | 0.0192 | 0.0011 |
| Eisosomes | 0.0006 | 0 | 0.0005 | 0.0003 | 0.0001 | 0.0004 | 0.0007 | 0 | 0.0005 | 0.0001 | 0 | 0 | 0.0003 | 0.0001 | 0.0002 | 0.0001 | 0.0011 | 0 |
| Endoplasmic Reticulum | 0.0361 | 0.014 | 0.0199 | 0.0031 | 0.002 | 0.0065 | 0.0301 | 0.01 | 0.009 | 0.0051 | 0.0026 | 0.005 | 0.0337 | 0.002 | 0.0054 | 0.0054 | 0.0048 | 0.0024 |
| Endosome | 0.0081 | 0.0018 | 0.0049 | 0.0034 | 0.0156 | 0.0115 | 0.0068 | 0.0021 | 0.0045 | 0.006 | 0.0156 | 0.0058 | 0.0058 | 0.0015 | 0.0031 | 0.0029 | 0.0679 | 0.0026 |
| Golgi | 0.0016 | 0.0004 | 0.0007 | 0.0003 | 0.0034 | 0.0005 | 0.0016 | 0.0007 | 0.0007 | 0.0007 | 0.0011 | 0.0002 | 0.0012 | 0.0002 | 0.0009 | 0.0002 | 0.0226 | 0.0002 |
| Lipid Particles | 0.0068 | 0.0023 | 0.0043 | 0.0011 | 0.0033 | 0.0027 | 0.0024 | 0.0008 | 0.0026 | 0.0007 | 0.0005 | 0 | 0.0026 | 0.0004 | 0.0022 | 0.0025 | 0.0128 | 0.0001 |
| Mitochondria | 0.0123 | 0.0011 | 0.0074 | 0.0294 | 0.0057 | 0.0168 | 0.0141 | 0.005 | 0.0137 | 0.0089 | 0.0016 | 0.0009 | 0.0226 | 0.0014 | 0.006 | 0.0013 | 0.0466 | 0.0033 |
| None | 0.0056 | 0.0002 | 0.0043 | 0.0012 | 0.001 | 0.0062 | 0.0023 | 0.0005 | 0.0018 | 0.0004 | 0.0005 | 0.0002 | 0.0042 | 0.0004 | 0.0028 | 0.0021 | 0.0175 | 0.0013 |
| Nuclear Periphery | 0.0324 | 0.0087 | 0.0117 | 0.0066 | 0.0134 | 0.0175 | 0.0428 | 0.0036 | 0.0095 | 0.0118 | 0.0079 | 0.0046 | 0.0352 | 0.0034 | 0.012 | 0.0283 | 0.0241 | 0.0359 |
| Nucleolus | 0.0159 | 0.0006 | 0.0094 | 0.0067 | 0.0042 | 0.1541 | 0.0028 | 0.0006 | 0.0065 | 0.0021 | 0.0015 | 0 | 0.0053 | 0.0011 | 0.0103 | 0.0045 | 0.0406 | 0.0054 |
| Nucleus | 0.0135 | 0.0038 | 0.0093 | 0.0098 | 0.029 | 0.0387 | 0.0142 | 0.0028 | 0.0087 | 0.0067 | 0.0158 | 0.004 | 0.0183 | 0.004 | 0.0113 | 0.0152 | 0.0116 | 0.0771 |
| Peroxisomes | 0.0015 | 0 | 0.0024 | 0.0004 | 0.0011 | 0.0003 | 0.0002 | 0.0001 | 0.0005 | 0.0001 | 0.0001 | 0 | 0.0008 | 0.0001 | 0.0031 | 0.0001 | 0.0021 | 0.0001 |
| Punctate Nuclear | 0.0016 | 0 | 0.0008 | 0.0001 | 0.0007 | 0.0004 | 0.0002 | 0 | 0.0003 | 0 | 0.0001 | 0 | 0.0063 | 0 | 0.0004 | 0.0002 | 0.001 | 0.0002 |
| Vacuole | 0.1907 | 0.1412 | 0.1535 | 0.2745 | 0.1905 | 0.2382 | 0.152 | 0.0666 | 0.1225 | 0.1906 | 0.2018 | 0.0151 | 0.1262 | 0.0578 | 0.0922 | 0.2243 | 0.084 | 0.0687 |
| Vacuole Periphery | 0.0335 | 0.0125 | 0.0267 | 0.0764 | 0.0773 | 0.2081 | 0.0361 | 0.0088 | 0.0257 | 0.0633 | 0.0713 | 0.0061 | 0.0361 | 0.0121 | 0.0334 | 0.0301 | 0.0582 | 0.0728 |
Sequencing Data
| R1 | R2 | |||||||||
|---|---|---|---|---|---|---|---|---|---|---|
| G1 Post-START | S/G2 | Metaphase | Anaphase | Telophase | G1 Post-START | S/G2 | Metaphase | Anaphase | Telophase | |
| Gene Expression | 8381.6299 | 10597.2209 | 15089.0943 | 7495.2046 | 13865.9326 | 14802.8833 | 9087.7947 | 9980.3939 | 14795.6837 | 7201.948 |
| Translational Efficiency | 2.4131 | 2.1354 | 1.287 | 4.1145 | 1.6052 | 1.1915 | 1.9337 | 2.0407 | 1.1932 | 2.1524 |
Hit Data
| Dataset | Hit |
|---|---|
| Protein Concentration | ✘ |
| Protein Localization | ✘ |
| Gene Expression | ✘ |
| Translational Efficiency | ✘ |
Endocytosis
| Temp | Actin Patch (Sac6-tdTomato) | Cortical Patch (Sla1-GFP) | Late Endosome (Snf7-GFP) | Vacuole (Vph1-GFP) |
|---|---|---|---|---|
| 37℃ | ||||
| RT |
Cell Cycle Omics
CYCLoPs (Rpl41b-GFP)
| Gene / Allele | Actin Patch (Sac6-tdTomato) | Cortical Patch (Sla1-GFP) | Late Endosome (Snf7-GFP) | Vacuole (Sac6-tdTomato) |
|---|
| Gene | Images |
|---|
| Gene | Images |
|---|
Images are not yet available
Images are not yet available